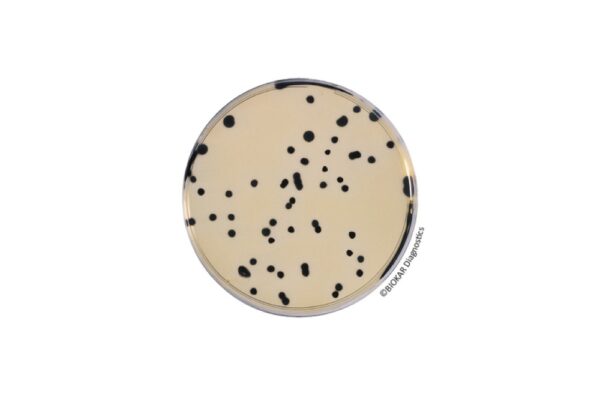
Image_TEC_INS_Biokar_Dehydrated_02_1000x665_JPG Image_TEC_INS_Biokar_Dehydrated_02_1000x665_JPG

Biokar – Microbiology – Dehydrated culture media
Biokar Diagnostics is the microbiology division of the Solabia group, dedicated to the development, production and selling of culture media, supplements and detection kits for microbiology laboratories.
Available Models

| Model name | Description | Packaging |
|---|---|---|
| Wilkins Chalgren Agar | Wilkins Chalgren Agar is used to determine the minimal inhibitory concentrations of antibiotics for anaerobic bacteria by the dilution method. It can also be used for the abundant growth and isolation of anaerobic bacteria. | BK101HA – 500 g bottle |

| Model name | Description | Packaging |
|---|---|---|
| Bacillus cereus Agar(Acc. To Mossel) | Bacillus cereus Agar is used for the detection and enumeration of spores and vegetative cells of Bacillus cereus in food products. The typical composition corresponds to the MYP agar (mannitol, egg yolk, polymyxin agar) described in the standards NF EN ISO 7932 and NF EN ISO 21871. | BK116HA – 500 g bottle |
| BCP Dextrose Agar | BCP Dextrose Tryptone Agar (also known as BCP Glucose agar) is used to enumerate mesophilic and thermophilic aerobic bacterial spores (especially Bacillus stearothermophilus, responsible for flat sour) in raw materials and in ingredients used in canning non-acid products (pH > 4,5). It is also used in surface samples and canning process water. | BK042HA – 500 g bottle |
| COMPASS® Bacillus cereus Agar / COMPASS® Bacillus Plus Agar | COMPASS® Bacillus cereus Agar is a solid medium used for the detection and the enumeration of spores and vegetative forms of presumptive species belonging to the group Bacillus cereus in products destined for human and animal consumption. COMPASS® Bacillus Plus Agar is obtaine by adding nutritive supplement to COMPASS® Bacillus cereus Agar. This media permit to reduce the incubation time to 21h and it allows too the recovery of all strains of the Bacillus cereus group, including Bacillus cytotoxicus. | BK189HA – 500 g bottle |
| Tryptone-Soy Agar | Tryptone-Soy Agar, used as a base to be supplemented with blood, is prepared with selected starting materials which do not turn brown. It was specially designed to detect beta-hemolytic reactions and to favor the growth of particularly fastidious aerobic and anaerobic bacteria. The media can be used for the hemolysis test on presumed colonies of Bacillus cereus, according to the standard ISO 21871. | BK028HA – 500 g bottle |

| Model name | Description | Packaging |
|---|---|---|
| Bryant and Burkey Broth with Resazurin (modified by Bergère) | Bryant and Burkey Broth with Resazurin (modified by Bergère) is used to enumerate the spores of lactate fermenting Clostridium in milk and dairy products. In particular, it is used to detect Clostridium tyrobutyricum, responsible for the late blowing of cheeses such as gruyère, emmental, gouda, edam, cheddar or parmesan. | BK141HA – 500 g bottle BK141GC – 5 kg drum |
| Lactose-Sulfite (LS) Broth | Lactose-Sulfite Broth is a confirmation medium allowing the selective detection of both the vegetative cells and spores of Clostridium perfringens in food products and biological samples of animal origin, without the usual confirmatory tests. | BK140HA – 500 g bottle |
| Reinforced Clostridial Agar | Reinforced Clostridial Agar is a non-selective medium used for the isolation and enumeration of Clostridia, other anaerobic bacteria and lactobacilli in biological samples, dairy products, and other food products. | BK090HA – 500 g bottle |
| Thioglycollate Medium with Resazurin | Thioglycollate Medium with Resazurin is used for sterility tests of biological products and for the culture of aerobic, anaerobic and microaerophilic bacteria. This medium is also used for the confirmation of Clostridium perfringens in food products. | BK017HA – 500 g bottle |
| TSC Agar | TSC Agar was described by Harmon for the selective isolation and enumeration of Clostridium perfringens in water and food samples. The medium was recommended for the enumeration of sulfur-reducing anaerobes from foods of animal origin. | BK031HA – 500 g bottle |

| Model name | Description | Packaging |
|---|---|---|
| Brilliant Green Bile Broth (BGBB) | Brilliant Green Bile Broth (BGBB) is used for the confirmation of coliforms and thermotolerant coliforms in food products, water used for watering food products and for effluent / run-off water testing. It can also be used as an enumeration media for coliforms in frozen dairy and ice cream products. | BK002HA – 500 g bottle |
| Bromocresol Purple (BCP) Lactose Agar | Bromocresol Purple (BCP) Lactose Agar is a non-selective medium, used for the differentiation of Enterobacteriaceae. It is used for the confirmation of coliforms in the context of the standard T90-425, for the bacteriological examination of containers and recipients used in water bottling. | BK023HA – 500 g bottle |
| Bromocresol Purple (BCP) Lactose broth | Bromocresol Purple (BCP) Lactose broth is used as enrichment media for the enumeration of coliforms and of thermotolerant coliforms in water. | BK119HA – 500 g bottle |
| COMPASS® cc Agar | COMPASS® cc Agar allows the direct enumeration of Escherichia coli and coliforms in water by membrane filtration in 24 hours, without the typical confirmation tests as oxidase detection or indole production from tryptophan. | BK210HA – 500 g bottle |
| COMPASS® Ecc Agar | The chromogenic media COMPASS® Ecc Agar is a selective agar for the simultaneous and specific enumeration without confirmation of Escherichia coli and of other coliform bacteria in human and animal food. | BK202HA – 500 g bottle |
| Desoxycholate (0.1%) Lactose Agar | Desoxycholate (0.1%) Lactose Agar is a selective medium for the enumeration of coliform bacteria in milk, dairy products and other food products. The medium is also recommended for the isolation and culture of Shigella. | BK062HA – 500 g bottle |
| Desoxycholate Lactose Agar | Desoxycholate Lactose Agar is a selective medium for the enumeration of coliform bacteria in water, milk, dairy and other food products. The medium is also used for the differentiation and isolation of enterobacteria from samples of animal origin. | BK065HA – 500 g bottle |
| Endo Agar | Endo Agar is used for the confirmation of the presence of coliforms and/or thermotolerant coliforms in drinking water, in milk, in dairy products and in other foods. | BK057HA – 500 g bottle |
| Lactose Broth | Lactose Broth is used principally as a liquid enrichment media for the detection of Escherichia coli in cosmetic products, if neutralizers or dispersal agents are not necessary. It is also adapted to the culture of all Gram negative bacteria. Armed with a Durham tube, it can detect the fermentation of lactose. | BK082HA – 500 g bottle |
| Laurylsulfate-Tryptose broth | Laurylsulfate-Tryptose broth is a selective enrichment media used for the detection and enumeration of Escherichia coli and coliforms in water and food products. | BK010HA – 500 g bottle |
| Tergitol 7 Agar | Tergitol 7 Agar is used for the enumeration of Escherichia coli and coliform bacteria in water, notably potable water, through the membrane filtration method. This media is also used for testing swimming pool water. | BK123HA – 500 g bottle |
| Violet Red Bile (VRBL) Agar | Violet Red Bile Agar (VRBL) is a selective medium used for the detection and enumeration of coliform and thermotolerant coliforms food products. | BK152HA – 500 g bottle BK152GC – 500 g drum |

| Model name | Description | Packaging |
|---|---|---|
| COMPASS® Enterobacter Sakazakii Agar | The COMPASS® Enterobacter sakazakii Agar is used for the detection of Cronobacter sakazakii and spp. in milk powder, dehydrated products and their components found in infant foods. | BK188HA – 500 g bottle |
| CSD method | The CSD method allows the rapid detection of Cronobacter spp in human food products (especially milk powders and infant ingredients) and products from the production environment. At the end of an enrichment phase with Salmonella Enrichment + CSD supplement, a subculture is carried out on CCI agar. The characteristic colonies will be confirmed. | BK194HA – 500 g bottle |
| mLST/V broth | mLST/V broth is a selective enrichment medium used for the detection of Cronobacter sakazakii in milk and milk products. | BK190HA – 500 g bottle |

| Model name | Description | Packaging |
|---|---|---|
| Buffered Peptone Water | Buffered Peptone Water is a general use diluent destined for numerous operations and standards including sample preparation, the preparation of stock suspensions and serial dilutions of samples. This media is also used for the pre-enrichment of Salmonella and for Cronobacter sakazakii, by allowing the resuscitation of microorganisms having undergone sublethal treatments as in the case of spray drying, pasteurization, action of conservators, elevated osmotic pressure and high acidity. It is used as a suspension and resuscitation media for the enumeration of Listeria monocytogenes. | BK131HA – 500 g bottleBK131GC – 5 kg drumBK018HA – 500 g bottleBK018GC – 5 kg drum |
| Buffered Peptone Broth with sodium chloride pH 7.0 | Buffered Peptone Broth with sodium chloride pH 7.0 is a diluent used to prepare stock solutions or suspensions of water-soluble or non-lipid water-insoluble pharmaceutical products. The medium is also used to rinse membranes when the filtration method is used to enumerate bacteria, yeasts and molds on the surface of appropriate agar media.. The diluent can also be used for stock solutions in the normalized methods for microbiological analysis of cosmetic products. | BK128HA – 500 g bottle |
| Eugon LT 100 broth | Eugon LT 100 broth is used as a neutralizing diluent and as an enrichment media for microorganisms in cosmetic products with and without preservatives. The typical formula corresponds to that defined in all the cosmetic standards cited as references in the bibliography. | BK137HA – 500 g bottle |
| Tryptone-Salt Broth | Tryptone-Salt Broth is a diluent used to prepare stock solutions of food and dairy products as well as cosmetics in preparation for microbiological analysis. It is also used to prepare serial dilutions. | BK014HA – 500 g bottle |

| Model name | Description | Packaging |
|---|---|---|
| Bromocresol Purple (BCP) Lactose Agar | Bromocresol Purple (BCP) Lactose Agar is a non-selective medium, used for the differentiation of Enterobacteriaceae. It is used for the confirmation of coliforms in the context of the standard T90-425, for the bacteriological examination of containers and recipients used in water bottling. | BK023HA – 500 g bottle |
| Drigalski Lactose agar | Drigalski Lactose agar is used for the selective isolation of Enterobacteriaceae. It allows the differentiation of bacteria according to their ability to ferment lactose in food, pharmaceutical, cosmetic and veterinary samples. | BK036HA – 500 g bottle |
| EE Broth Acc. To Mossel | EE Broth, buffered and containing bile salts, brilliant green and glucose, proposed by Mossel, is a selective enrichment media for the enumeration by Most Probable Number of Enterobacteriaceae in food, animal and environmental products. | BK127HA – 500 g bottle |
| Kligler Iron Agar | Kligler Iron Agar is used for the identification of enterobacteria by the rapid detection of lactose and glucose fermentation (with or without gas production), as well as the production of hydrogen sulfide. | BK034HA – 500 g bottle |
| MacConkey agar | MacConkey agar is a selective medium for the isolation of enterobacteria in water, food, pharmaceutical products and biological samples of animal origin and in cosmetic products. | BK050HA – 500 g bottle |
| TSI (Triple Sugar Iron) Agar | TSI (Triple Sugar Iron) Agar is used for the identification of enterobacteria by the rapid detection of the fermentation of lactose, glucose (with or without gas production) and of sucrose, as well as the production of hydrogen sulfide. | BK059HA – 500 g bottle |
| VRBG Agar | Violet Red Bile Glucose Agar containing crystal violet and neutral red (VRBG Agar) was used by Mossel for the detection and enumeration of enterobacteria in dairy products, meat, prepared pork products and other food products. The media can also be used for the detection of Gram negative, bile resistant bacteria during the microbiological control of non-sterile products. | BK011HA – 500 g bottle BK011GC – 5 kg drum |
| MacConkey Sorbitol (CT-SMAC) Agar | MacConkey Sorbitol (CT-SMAC) agar is a selective media used for the isolation and differentiation of Escherichia coli O157 in water, milk, beef products and other food preparations. | BK147HA – 500 g bottle |
| Modified Tryptone-Soy Broth (MTSB) | Modified Tryptone-Soy Broth (MTSB) is an enrichment medium destined for the detection of pathogenic serotypes of Escherichia coli, in particular the O157:H7 serotype, in food products and other potentially contaminated samples from animal origin. | BK150HA – 500 g bottle |

| Model name | Description | Packaging |
|---|---|---|
| Azide Dextrose Broth (Acc. To Rothe) | Azide Dextrose Broth (Rothe) is used for the enumeration of enterococci in drinking water, frozen foods and other food products by the most probable number method. | BK060HA – 500 g bottle |
| BEA agar (Bile, Esculin, Azide) | Bile Esculin Azide Agar (BEA agar) is a selective medium used to isolate and enumerate enterococci in food and pharmaceutical products. It is also used for the enumeration of enterococci animal feed. | BK158HA – 500 g bottle |
| COMPASS® Enterococcus Agar | COMPASS® Enterococcus Agar is a selective media used for the enumeration of enterococci in food and water. | BK183HA – 500 g bottle |
| Ethyl Violet Azide Broth (Litsky broth) | Ethyl Violet Azide Broth (also known as Litsky broth) is used to carry out the confirmation test of the detection and enumeration of fecal streptococci (enterococci) in drinking water and waste water, in frozen foods and other food products by the most probable number method. | BK061HA – 500 g bottle |
| KF (Kenner Fecal) Streptococcus Agar | KF (Kenner Fecal) Streptococcus Agar is a selective medium used for the isolation and enumeration of enterococci in food products by using classic enumeration techniques on Petri plates. | BK132HA – 500 g bottle |
| Slanetz and Bartley Agar | Slanetz and Bartley Agar is a selective medium used for the enumeration of intestinal enterococci in drinking water, beverages, waste water, swimming pool water and various biological products of animal origin, by the membrane filtration method. | BK037HA – 500 g bottle |

| Model name | Description | Packaging |
|---|---|---|
| Chromogenic Coliform Agar (CCA) | Chromogenic Coliform Agar (CCA) is used for the detection and enumeration of Escherichia coli and coliform bacteria in waters of low bacterial numbers (less than 100 total colonies). These waters can be drinking water, disinfected pool water or finished water from treatment plants. | BK204HA – 500 g bottle |
| EC Broth | EC Broth (abbreviation for Escherichia coli) is a selective media used for the confirmation of E. coli in water, milk and other food products, as well as live shellfish. The typical composition of the broth responds to that defined in the normalized method of presumptive Escherichia coli enumeration. | BK162HA – 500 g bottle |
| EMB Agar | EMB Agar, originally recommended by Levine, is used to isolate and identify enterobacteria (notably Escherichia coli and Enterobacter aerogenes) in pharmaceutical, cosmetic and food products as well as water. | BK056HA – 500 g bottle |
| Glutamate broth | Glutamate broth is used enumeration of β-glucuronidase positive E. coli in food products by the MPN technique. It is recommended when the microorganisms are found in a sub-optimal state due to exposition to stress including freezing, desiccation, disinfection or high salinity. | BK034HA – 500 g bottle |
| MacConkey Broth Purple | MacConkey Broth Purple complies with the formula described in the European Pharmacopoeia for the detection of Escherichia coli in non-sterile products. The media may be also used as a presumptive medium for the detection of coliform bacteria in water, milk, and seafood (oysters). | BK107HA – 500 g bottle |
| Peptone water | Peptone water is used for the culture of microorganisms with no particular growth requirements. This media is specifically used for the Mackenzie test for the identification of Escherichia coli via indole production. | BK084HA – 500 g bottle |
| TBX Agar | TBX Agar is a selective medium for the enumeration of β-D-glucuronidase-positive Escherichia coli in food products. The result is obtained directly by counting characteristic colonies after only 24 hours of incubation and no confirmation step is required. | BK146HA – 500 g bottle BK146HM – 100 g bottle |
| MacConkey Sorbitol (CT-SMAC) Agar | MacConkey Sorbitol (CT-SMAC) agar is a selective media used for the isolation and differentiation of Escherichia coli O157 in water, milk, beef products and other food preparations. | BK147HA – 500 g bottle |
| Modified Tryptone-Soy Broth (MTSB) | Modified Tryptone-Soy Broth (MTSB) is an enrichment medium destined for the detection of pathogenic serotypes of Escherichia coli, in particular the O157:H7 serotype, in food products and other potentially contaminated samples from animal origin. | BK150HA – 500 g bottle |

| Model name | Description | Packaging |
|---|---|---|
| Elliker Broth | Elliker Broth, prepared according to the formula of Elliker, Anderson and Hannesson, contains the nutritive elements necessary for the growth of lactobacilli and lactic streptococci (including Lactococcus) in dairy products. | BK054HA – 500 g bottle |
| M17 Agar | M17 Agar is used for the enumeration of lactococci (especially Lactococcus lactis) in dairy products. It is also used to study the sensitivity of these species to bacteriophages. It is well adapted to the enumeration of Streptococcus thermophiles in natural or flavored yogurts, textured or not, and in yogurts containing morsels of fruit. | BK088HA – 500 g bottle |
| M17 Broth | M17 Broth was developed for the growth and enumeration of lactic streptococci (lactococci) in milk and dairy products. It favors the growth of mutants unable to ferment lactose. It is well adapted to the culture of Lactococcus lactis (a particularly fastidious species). | BK012HA – 500 g bottle |
| MRS Agar | MRS Agar is used for the growth and enumeration of cultures of Lactobacillus in dairy and other food products as well as in products destined for animal feed. | BK089HA – 500 g bottle |
| MRS Broth | MRS Broth is used for the growth and enumeration of lactobacilli in food products. By transferring isolated colonies, luxuriant subcultures can be obtained. The medium can also be used to culture slowly-growing lactobacilli such as Lactobacillus brevis and Lactobacillus fermentum. | BK070HA – 500 g bottle |
| MSE Agar (Mayeux, Sandine & Elliker) | This medium, developed by Mayeux, Sandine and Elliker in 1962, is an elective medium for the detection and enumeration of Leuconostoc in milk, dairy products and sweet foods. | BK087HA – 500 g bottle |
| Non-Animal MRS Broth | The Non-Animal version of MRS broth is used primarily for the growth of lactobacilli or lactic acid bacteria via industrial fermentation for use as starter cultures in varying food, cosmetic or pharmaceutical products. By substituting all animal peptones with non-animal equivalents, the regulatory and safety concerns arising from bovine spongiform encephalothopy and related pathologies can be successfully eliminated, making the medium an ideal fermentative formula providing excellent growth | BK176HA – 500 g bottle |
| Reinforced Clostridial Agar | Reinforced Clostridial Agar is a non-selective medium used for the isolation and enumeration of Clostridia, other anaerobic bacteria and lactobacilli in biological samples, dairy products, and other food products. | BK090HA – 500 g bottle |
| Rogosa Agar | Rogosa Agar is a selective medium used for the enumeration of lactobacilli in meat, food products and biological samples of animal origin. Given its high concentration in salts, the media is not adapted to the isolation of certain dairy lactobacilli such as Lactobacillus delbrueckii subsp. lactis or Lactobacillus delbrueckii subsp. bulgaricus. | BK033HA – 500 g bottle |

| Model name | Description | Packaging |
|---|---|---|
| COMPASS® Listeria constitutes | COMPASS® Listeria constitutes a method constitutes a method for the detection of Listeria monocytogenes and of Listeria spp, and a method for the enumeration of Listeria monocytogenes in food products, and in environmental samples even heavily contaminated. | BK192HA – 500 g bottle |
| Fraser Broth | Fraser broth is used for the selective secondary enrichment of Listeria monocytogenes and other Listeria in food products | BK115HA – 500 g bottle |
| Listeria Enrichment Broth (LEB Acc. To IDF) | LEB media (Listeria Enrichment Broth) according to the International Dairy Federation (IDF) is used for the selective enrichment of Listeria in milk and dairy products. | BK124HA – 500 g bottle |
| Listeria Enrichment Broth (LEB Acc. To FDA) | LEB media according to FDA (Food and Drug Administration) is used for the selective enrichment of Listeria in milk, dairy products, meats, poultry and other food products. | BK112HA – 500 g bottle |
| Listeria Enrichment Broth (Modified UVM 1) | The enrichment broths UVM (University of Vermont) involve a 2 step process, leading to a higher degree of isolation of Listeria monocytogenes in meat products (including poultry). UVM 1 enrichment broth allows for primary enrichment of Listeria. | BK113HA – 500 g bottle |
| Oxford Agar | Oxford Agar is a selective medium used for the differentiation, the isolation and the enumeration of Listeria monocytogenes from milk and cheese, as well as in other food samples, even highly contaminated. | BK110HA – 500 g bottle |
| PALCAM Agar | PALCAM Agar is a selective medium used for the differentiation and isolation of Listeria monocytogenes and other Listeria, from milk and cheese, as well as in other food products, even highly contaminated. | BK145HA – 500 g bottle |
| TSYEA Agar | TSYEA is a universal medium used in a number of applications or protocols. Given its excellent nutritive value, it is often used for the isolation and purification of microorganisms obtained from selective media (i.e. PALCAM agar, Oxford agar, COMPASS® Listeria Agar, etc.) for detection or enumeration of Listeria, and more specifically, Listeria monocytogenes according to the standards currently in vigor. | BK224HA – 500 g bottle |

| Model name | Description | Packaging |
|---|---|---|
| CFC Agar | CFC Agar is a selective medium for the enumeration of Pseudomonas spp. that frequently contaminates meats and poultry-based products during their cold storage. The typical composition responds to the standard NF EN ISO 13720, for the enumeration of presumptive Pseudomonas in meats and meat-based products. | BK118HA – 500 g bottle |
| CN Agar for Pseudomonas | CN Agar for Pseudomonas is a selective medium for the isolation and enumeration of Pseudomonas aeruginosa in bottled water, swimming pools and water destined for human consumption. | BK165HA – 500 g bottle |
| RHAPSODY Agar® | RHAPSODY Agar® is a selective medium used for the enumeration of Pseudomonas spp. in food products and environmental samples. | BM16708 – 20 Petri plates Ø 90 mm |

| Model name | Description | Packaging |
|---|---|---|
| Bismuth Sulfite Agar | Bismuth Sulfite (modified Wilson Blair agar) Agar is a selective medium used to isolate Salmonella Typhi and other salmonellas in pathological products of animal origin, water, dairy and other food products. Bismuth Sulfite agar can be used in the normalized methods for Salmonella detection as the second isolation media. | BK004HA – 500 g bottle |
| Bismuth Sulfite Agar ISO 6579-1 | Bismuth Sulfite Agar ISO 6579-1 is a selective medium used to isolate Salmonella in water, dairy products and other food products. | BK223HA – 500 g bottle |
| Brilliant Green Agar (Kristensen) | Brilliant Green Agar of Kristensen is a highly selective medium used to isolate salmonella, except for Salmonella Typhi, in biological samples of animal origin and food products. The agar can also be used as the second media of choice in the normalized standards for the research and detection of Salmonella. | BK071HA – 500 g bottle |
| Brilliant Green Agar (Edel & Kampelmacher) | Brilliant Green agar according to Edel & Kampelmacher is a selective medium used to isolate Salmonella in milk and dairy products. This media can also be used as a second isolation media in the context of the various normalized methods for the detection of Salmonella spp. | BK091HA – 500 g bottle |
| Hektoen Enteric Agar | Hektoen Enteric Agar is a selective medium for the isolation and differentiation of pathogenic enterobacteria from biological samples of animal origin, water samples, dairy products and other food products. It is used in animal health in the context of Salmonella detection in mammals. | BK067HA – 500 g bottle |
| IRIS Salmonella® | IRIS Salmonella® is an alternative research method of Salmonellae in human food and feeds, and environmental sample (except primary production samples). Studies performed on IRIS Salmonella® Agar show a high specificity for the detection of Salmonellae including atypical species and serovars, which is a source of confusion on other medium. | IRIS Salmonella® |
| MSRV Medium | Modified Semi-Solid Rappaport-Vassiliadis Agar (MSRV) is a selective medium historically used for the isolation of Salmonella in chocolate and other food products. It is also widely used in animal health: in particular with mammals, poultry and in animal production facilities. It is also recommended for us in the detection of motile Salmonellae in animal fecal matter and in environmental samples in the context of primary animal production. | BK191HA – 500 g bottle |
| Müller & Kauffmann broth | Müller & Kauffmann Tetrathionate broth is one the oldest media traditionally used for the selective enrichment of Salmonella. | BK135HA – 500 g bottle |
| Rappaport-Vassiliadis Soja (RVS) Broth | Rappaport-Vassiliadis Soja Broth is used for the selective enrichment of Salmonella in milk, dairy products, other food products, water and in environmental samples. | BK148HA – 500 g bottle |
| Salmonella Enrichment | Salmonella Enrichment is a special formulation of Buffered Peptone Water that has been created and controlled for optimal detection of Salmonella in food products and feed. | BK194HA – 500 g bottle BK194CG – 5 kg drum |
| Salmonella-Shigella (SS) Agar | Salmonella-Shigella (SS) agar is used for the isolation of Salmonellae and Shigellae in fecal material. It can also be used as a second media of isolation in the context of standardized methods for the detection of Salmonella. | BK022HA – 500 g bottle |
| Selenite-Cystine Broth | Selenite-Cystine broth is used for the selective enrichment of Salmonella in milk and dairy products but also for the characterization of residual sludge It can also be used in animal health for the detection of Salmonella Gallinarum or in water testing. | BK009HA – 500 g bottle |
| SESAME Salmonella TEST® | SESAME Salmonella TEST® represents an alternative method for the detection of Salmonella in human and animal products, as well as environmental samples (with the exception of those from animal production). This method is destined to the detection of motile Salmonella, and is not adapted to non-motile Salmonella (non-motile strains or that have lost their mobility. | BK195HA – 500 g bottle |
| Tryptophan Broth | Tryptophan broth allows the culture of microorganisms presenting no particular growth requirements. The media is used to perform the indole production test, used notably in the confirmation of Escherichia coli, Shigella and Salmonella. | BK163HA – 500 g bottle |
| XLD (Xylose Lysine Desoxycholate) Agar | XLD (Xylose Lysine Desoxycholate) Agar is used for the isolation of Salmonella in pharmaceutical products. The typical composition corresponds to that defined in the American and European Pharmacopeia. | BK058HA – 500 g bottle |
| XLT4 (Xylose-Lysine-Tergitol 4) Agar | XLT4 (Xylose-Lysine-Tergitol 4) Agar is a selective isolation medium for the detection of Salmonella, except for Salmonella Typhi and Paratyphi. It can be used as the second media of choice in the normalized methods of Salmonella detection in food microbiology. It is also used as media of choice in animal health for Salmonella detection. | BK156HA – 500 g bottle |

| Model name | Description | Packaging |
| Baird-Parker Agar with Egg Yolk Tellurite | Baird-Parker Agar with egg yolk and potassium tellurite is a selective medium for the detection and enumeration of Staphylococcus aureus in animal origin biological samples, pharmaceutical products, cosmetics, foods and water. | BK055HA – 500 g bottle BK055GC – 5 kg drum |
| Baird Parker RPF Agar | Baird Parker RPF (RPF = Rabbit Plasma Fibrinogen) Agar is used for the direct detection and enumeration of coagulase positive staphylococci. The medium has the advantage of considerably reducing the number of confirmation tests for the presence of coagulase positive staphylococci particularly when atypical colonies are observed on other selective media. | BK055HA – 500 g bottle BK055GC – 5 kg drum |
| Brain-Heart Broth | Brain-Heart Broth is a buffered nutrient medium used for the culture of a wide variety of aerobic and anaerobic microorganisms including yeasts and molds. It is suitable for the detection of staphylocoagulase. | BK015HA – 500 g bottle |
| Buttiaux-Brogniart Hypersalted Broth | Buttiaux-Brogniart Hypersalted Broth is a double strength enrichment medium for the detection of Staphylococcus aureus in food products, particularly in gelatin used for food and other uses. | BK081HA – 500 g bottle |
| Giolitti & Cantoni Broth with Tween 80 (Base) | Giolitti and Cantoni Broth with Tween 80 is a selective enrichment medium for the detection and enumeration (particularly in low numbers) of coagulase positive staphylococci in food products. | BK159HA – 500 g bottle |
| Mannitol Salt Agar | Mannitol Salt agar is used for the selective isolation, detection and enumeration of pathogenic staphylococci in filterable water as in swimming pools, potable water or spas. It is also used for the detection of Staphylococcus aureus according to the Pharmacopeia and in cosmetic products. | BK030HA – 500 g bottle |

| Model name | Description | Packaging |
|---|---|---|
| Iron Sulfite Agar (TSC Agar Base) | Iron sulfite agar is a media used for the enumeration of sulfite-reducing anaerobes in food microbiology but also in water. The agar base can also be used with TSC Agar for the more specific detection of Clostridium perfringens (refer to the technical data sheet for TSC Agar). | BK031HA – 500 g bottle |
| Meat-liver Glucose Agar | Meat-liver Glucose Agar is used to enumerate spores of sulfite-reducing anaerobic bacteria in water. | BK157HA – 500 g bottle |
| Meat-Yeast Agar | Meat-Yeast Agar is used to enumerate spores of sulfite-reducing anaerobic bacteria in gelatin and other food products. The typical composition corresponds to that defined in the standard NF V59-106. | BK006HA – 500 g bottle |
| TSN agar | TSN agar is primarily used for the detection and enumeration of sulfur-reducing microorganisms at 46°C in certain food products, notably in pre-cooked packaged meals. | BK001HA – 500 g bottle |

| Model name | Description | Packaging |
|---|---|---|
| Cetrimide Agar | Cetrimide Agar is a selective medium for the isolation and enumeration of Pseudomonas aeruginosa in biological samples of animal origin and in pharmaceutical and cosmetic products. | BK049HA – 500 g bottle |
| Contact Plate Agar | Contact Plate Agar is used to enumerate microorganisms by the direct application of the agar to the surfaces to test. The use of this simplified technique is a good verification of the state of cleanliness of equipment after cleaning and disinfection. It can also be used to determine the bacterial load on the hands and fingers of personnel. | BK130HA – 500 g bottle |
| Eugon Broth | Eugon Broth is used to obtain luxuriant cultures (eugonic) with a wide variety of microorganisms including the most fastidious, with yeasts and with molds. It is used for the detection and growth of lactic acid bacteria from meats and other food products. It is appropriate in industrial microbiology for antigen production. | BK068HA – 500 g bottle |
| Eugon LT 100 Agar | Eugon LT 100 agar is used for the enumeration of total mesophilic aerobic microorganisms in cosmetic products with or without preservatives. It enables luxuriant colonies to form in the case of most microorganisms. | BK138HA – 500 g bottle |
| Non-Animal Tryptic Soy Broth | Non-Animal Tryptic Soy broth is a universal nutrient medium that can be used for a wide range of uses. Given its excellent nutritive value, it favors the culture of a wide variety of microorganisms. Particular applications of Non-Animal Tryptic Soy broth are in the cosmetic, agro-food and pharmaceutical industries for sterility control where the presence of animal and/or bovine origin products is of concern. | BK180HA – 500 g bottle |
| Nutrient Agar (2.5%) | Nutrient Agar (2.5%) is used primarily in water microbiology for the culture of microorganisms in the context of purification steps required in certain specific standard or protocols of detection and/or enumeration. Use of this media leads to well isolated colonies. | BM12508 – 50 tubes of 18 mL |
| Plate Count Agar with Skimmed Milk | Plate Count Agar with skimmed milk is used in food and dairy bacteriology to enumerate aerobic bacteria in milk powders and dairy products. It is also used in the enumeration of psychrotrophic microorganisms. | BK161HA – 500 g bottle |
| Plate Count Agar (PCA) | Plate Count Agar containing glucose and yeast extract is used in food bacteriology to enumerate aerobic bacteria in milk, meats, meat-based products, other food products, as well as for the analysis of pharmaceuticals, cosmetics and their associated raw materials. | BK144HA – 500 g bottle BK144GC – 5 kg drum |
| R2A Agar | The R2A (Reasoner’s 2A) agar is a medium destined for the enumeration of total viable aerobic microorganisms in treated water such as purified water, highly purified water and water for injectable preparation. | BK179HA – 500 g bottle |
| Sugar-Free Agar (SFA) | Sugar-Free Agar for the enumeration of contaminants in dairy products is a carbohydrate-free medium used for the detection and enumeration of microorganisms that do not undergo specific fermentation processes during the preparation of dairy products. The result of the enumeration furnishes an indication of the level of contamination of the sample tested. | BK126HA – 500 g bottle |
| Trypto-Casein Soy Agar (TSA) | Trypto Casein-Soy Agar is a universal nutrient medium suitable for a wide range of uses. In light of its excellent nutritive value, it can be used for the growth and isolation of both aerobic and anaerobic bacteria and to favor the development of the most fastidious microorganisms. | BK047HA – 500 g bottle |
| Tryptone-Casein Soy Broth (TSB) | Tryptone-Soy Broth is a universal nutrient medium suitable for a wide range of uses. In light of its excellent nutritive value, it favors the growth of most fastidious microorganisms. It is used in the pharmaceutical industry to satisfy sterility tests and its formula is that listed in the United States Pharmacopoeia for specific and non-specific germs. | BK046HA – 500 g bottle BK046GC – 5 kg drum |
| Yeast Extract Agar | Yeast Extract Agar is used in water microbiology for the enumeration of culturable microorganisms by colony count at 36 and 22°C. The method is intended to measure the functional efficiency of drinking water treatment, and more generally, all types of water. | BK153HA – 500 g bottle |

| Model name | Description | Packaging |
|---|---|---|
| Alkaline Saline Peptone Water (ASPW) | Alkaline saline peptone water (ASPW) is used as a primary and secondary enrichment medium for the detection of Vibrio spp. in human and animal food products as well as environmental samples. | BK219HA – 500 g bottle |
| Thiosulfate-Citrate-Bile-Sucrose (TCBS) Agar | Thiosulfate-Citrate-Bile-Sucrose Agar is a selective medium for the isolation of Vibrio cholerae and other enteropathologic Vibrio (in particular Vibrio parahaemolyticus) in fish, seafood and biological samples of animal origin. | BK040HA – 500 g bottle |

| Model name | Description | Packaging |
|---|---|---|
| CPLG Agar | CPLG Agar is destined for the detection and enumeration of yeasts and molds in food products. | BK007HA – 500 g bottle |
| Dichloran Rose Bengal CPL Agar | Dichloran Rose Bengal CPL agar is recommended for the enumeration of viable yeasts and molds that develop in products destined for human and animal consumption with a water activity (aw) greater than 0.95. | BK198HA – 500 g bottle |
| Dichloran-glycerol (DG-18) Agar | Dichloran-glycerol (DG-18) agar is recommended for the enumeration of yeasts and molds that develop in products with a low water activity (aw less than 0.95). The media finds particular applications for the enumeration and isolation of xerophilic molds which may be found in dehydrated or extremely dry products, such as heavily sugared or salted foods, dried fruits, cereals, cakes and cookies, flour and meat or fish based dehydrated products. | BK170HA – 500 g bottle |
| Malt Extract Agar | Malt Extract agar is used for the enumeration of yeasts and molds. It can also be used for the isolation and maintenance of strains. | BK045HA – 500 g bottle |
| Orange Serum Agar | Orange Serum Agar is used for the growth, isolation and enumeration of yeasts, molds and acid-tolerant bacteria (Bacillus, lactobacilli, Leuconostoc, Streptococcus, Clostridium), which are responsible for deteriorations in fruit juices and citrus concentrates. It has also been used for hygiene controls of industrial equipment used to prepare fruit-based beverages. | BK103HA – 500 g bottle |
| Oxytetracycline Glucose Agar (OGA) | Oxytetracycline Glucose Agar is used for the detection and enumeration of yeasts and molds in food products. | BK053HA – 500 g bottle BK053GC – 5 kg drum |
| Potato Dextrose Agar (PDA) | Potato Dextrose Agar (PDA) is recommended in standards applied to cosmetic products. It can be used as selective media after addition of CPL or for applicability trials. This media is also adapted to the growth of yeasts and molds. | BK095HA – 500 g bottle |
| Rose Bengal CPL Agar | Rose Bengal CPL Agar is recommended for the selective isolation and enumeration of yeast and molds in food products, environmental, and any other potentially contaminated samples of animal origin. | BK151HA – 500 g bottle |
| Sabouraud CPL Agar | Sabouraud CPL Agar is recommended for the isolation of yeasts and molds, especially when the samples are highly contaminated with bacteria. | BK027HA – 500 g bottle |
| Sabouraud Dextrose Agar | Sabouraud Dextrose Agar is a classical medium for the culture, isolation and identification of yeasts & molds in sterility tests of pharmaceutical and cosmetic products. It is also used in the specific detection of Candida albicans in pharmaceutical products. | BK025HA – 500 g bottle |
| Sabouraud Dextrose Broth | Sabouraud Dextrose Broth is recommended for the detection of Candida albicans in non-sterile products according to the harmonized Pharmacopeia. | BK026HA – 500 g bottle |
| Wort Agar | Wort Agar is used for the growth, isolation and enumeration of yeasts and molds. It is particularly well adapted to the enumeration of osmophilic yeasts in butter, sugar, syrups, lemonade and more generally in sweet beverages. | BK013HA – 500 g bottle |
Culture Media Production by BIOKAR Diagnostics
BIOKAR Diagnostics is an industry leader with 50 years of experience in microbiology and we got a chance to visit their factory! Follow Julien Pastor from DKSH Technology and Athanassios Giannakopoulos from BIOKAR to visit this modern factory and learn their production of culture media, from peptones to ready-to-use media.
Key Industries
- Agriculture
- Cosmetics & Personal Care
- Education & Academics
- Environmental
- Food & Beverage
- Medical
- Pharmaceutical
More Products
Biokar Diagnostics is the microbiology division of the Solabia group, dedicated to the development, production and selling of culture media,…